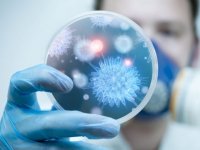

Новини за 17 листопада 2021 р.

17 листопада, 23:04 Новини
Луцька веслувальниця отримає стипендію Президента України
За 3-е місце на чемпіонаті Європи стипендію призначено луцькій веслувальниці Марії Повх.

17 листопада, 22:22 Новини
Сьогодні вночі буде унікальний зорепад: не втратьте шанс загадати бажання
У листопаді українці зможуть спостерігати унікальні природні явища – йдеться про зорепад Леоніди, а також місячне затемнення.

17 листопада, 22:12 Новини
Для тих, хто пропустив друге щеплення: на Волині запрацював «вакцинальний» колцентр
На базі ДУ «Волинський обласний центр контролю та профілактики хвороб» запрацював колцентр для особистого запису людей на щеплення.

17 листопада, 21:22 Новини
Волинь матиме унікальний календар фестивалів
На Волині планують створити календаря фестивалів, пам’ятних та ювілейних дат.

17 листопада, 20:36 Новини
На Волині фура знесла електроопору: село повністю знеструмило. ВІДЕО
Сьогодні зранку, 17 листопада, в селі Козин Луцького району вантажівка влетіла в електроопору та знищила її

17 листопада, 20:00 Новини
Погода у Луцьку та Волинській області на завтра, 18 листопада
У Луцьку хмарна погода буде триматися до самого вечора

17 листопада, 19:45 Новини
Вчені розповіли, скільки потрібно пити на день чашок кави та чаю
Експерти стежили за здоров'ям 500 учасників і перевагами в гарячих напоях понад 10 років

17 листопада, 19:19 Новини
Білорусь припиняє постачати електроенергію в Україну
Рішення прийняте в рамках встановленого порядку взаємодії за контрактом, який сторони підписали раніше

17 листопада, 19:00 Новини
Де у Луцьку завтра, 18 листопада, не буде світла
У Луцьку завтра, 18 листопада через монтаж техоблікута капремонт деякі вулиці залишаться без світла

17 листопада, 18:44 Новини
Розповіли, чому у Волинській обласній клінічній лікарні не поспішають із трансплантаціями органів. ВІДЕО
Передусім намагаються зробити заклад безпечним для пацієнтів

17 листопада, 18:26 Новини
Науковці довели, що погано почищені зуби і захворювання ротової порожнини підвищують ризик ускладнень COVID-19
Люди з парадонтитом у 4,5 рази частіше потребують апарату штучної вентиляції легень і в 9 разів частіше помирають від COVID-19

17 листопада, 17:50 Новини
Танцюристи з Волині – четверті на чемпіонаті світу зі спортивно-бальних танців
4 місце у чемпіонаті посіли вихованці клубу спортивного танцю Starlight Роман Боярчук з Володимира та Софія Гера з Нововолинська.

17 листопада, 17:40 Новини
Під Луцьком продається новий котедж: поруч – ліс та ставки*
Унікальна перевага локації - ліс просто навпроти будинку та зовсім поруч - Боголюбські ставки.

17 листопада, 17:20 Новини
Борг волинян за газ сягнув понад 400 мільйонів гривень
Лише жителі обласного центру заборгували за газ 175 мільйонів гривень

17 листопада, 16:50 Новини
Стало відомо, як нараховуватимуть тисячу гривень за вакцинацію від COVID
Ці гроші не оподатковуватимуться, а також не вплинуть на отримання субсидій.

17 листопада, 16:35 Новини
Волиняни здобули медалі на чемпіонаті Європи з кіокушинкай карате. ФОТО
У підсумку змагань волинські спортсмени показали високий рівень підготовки та здобули в скарбничку області 2 медалі

17 листопада, 16:12 Новини
Депутатка Луцькради закликає жінок йти в політику. ВІДЕО
Депутатка хоче на власному прикладі розвіяти стереотип про те, що політика – винятково чоловіча справа.

17 листопада, 16:00 Новини
У голови Волинської облради буде новий радник: хто він і які статки має
У голови Волинської обласної ради буде новий радник.

17 листопада, 15:52 Новини
У Луцьку на даху будинку затримали чоловіка з наркотиками
Волинські патрульні виявляють речовини, ймовірно, наркотичного походження

17 листопада, 15:40 Новини
«Жовтий мішок»: у Підгайцівській громаді вперше збирали вторсировину. ФОТО
Через два тижні збір «жовтих мішків» у Підгайцівській громаді повторять

17 листопада, 15:27 Новини
Повідомили, скільки працівників освітніх закладів на Волині досі відсторонені від роботи
Зараз 773 працівники волинських освітніх закладів не пройшли курсу вакцинації від коронавірусу

17 листопада, 15:13 Новини
На Волині фіксують ріст захворюваності на COVID-19 серед дітей
Всього на коронавірус захворіло 5754 дитини з початку епідсезону

17 листопада, 15:08 Новини
Стало відомо, коли Волинь зможе вийти з «червоної» зони
Епідситуація на Волині є досить напруженою.

17 листопада, 14:57 Новини
В СБУ оцінили ймовірність прориву білоруських мігрантів на Волинь
Про те, що правоохоронці почали посилено контролювати кордон із Білоруссю, говорять місцеві жителі

17 листопада, 14:49 Новини
Дерев'яні сходи на замовлення: що варто знати і які переваги*
Дерев'яні сходи в будинку – важлива частина будь-якого будівельного проєкту, вони слугують переходом між першим і другим поверхом.

17 листопада, 14:37 Новини
У волинських селах діють мобільні відділення «Укрпошти»: що кажуть жителі. ВІДЕО
В українських селах, де мешкає менше 1200 людей, поштових відділень більше немає

17 листопада, 14:20 Новини
На луцькому ринку торгували безакцизним алкоголем
Працівники Луцького РВП ГУНП у Волинській області вилучили з обігу 15 пляшок алкогольних напоїв на суму понад 1,05 тисячі гривень

17 листопада, 14:09 Новини
На Волині у багатодітної сім`ї згорів будинок
Подружжя виховує шестеро неповнолітніх дітей.

17 листопада, 13:51 Новини
На Волині розшукують шахрайку
Кому відома інформація про місцеперебування Діани Кравець, просять звертатися за телефонами 063-466-10-66 ; 050-207-72-00 або 102

17 листопада, 13:39 Новини
Розповіли, чому лучанам доводиться довго чекати маршрутку на зупинках. ВІДЕО
На деяких маршрутах, якими тепер їздять великі екологічні автобуси, поменшало одиниць транспорту

17 листопада, 13:20 Новини
На Волині учасники бойових дій можуть скористатися пільговим розмитненням «євроблях»
Здійснити митне оформлення таких авто у зоні діяльності Волинської митниці учасники бойових дій можуть на митних постах "Луцьк" або "Ковель".

17 листопада, 13:05 Новини
Обмеження для невакцинованих посилять і в «жовтих» зонах
МОЗ працює над змінами до постанови про адаптивний карантин.

17 листопада, 12:48 Новини
В Україні прийняли закон про штрафи за продаж ліків дітям
Верховна Рада України прийнала закон про встановлення відповідальності за продаж ліків дітям

17 листопада, 12:30 Новини
Волинська поліція розшукує злочинця, який переховується від органів суду
Його прикмети: на вигляд 40 років, зріст 180-185 см., спортивної тілобудови, коротке світле волосся, очі карі

17 листопада, 12:19 Новини
Поліщук пригрозив звільненням одному з очільників транспортного управління
Мер міста зауважив, що нерідко ввечері через відповідну систему моніторить, як їздить міський транспорт

17 листопада, 12:10 Новини
У Луцьку та громаді за три роки хочуть встановити понад 1100 камер відеоспостереження
Після того, як програму затвердять депутати під час сесії, її почнуть впроваджувати

17 листопада, 12:00 Новини
Шахраї ошукали волинянина на більш як 4 тис гривень під час інтернет-продажу
Майбутній покупець скинув фішингове повідомлення, а хлопець, заповнивши його, позбувся власних коштів на суму майже 4300 гривень.

17 листопада, 11:45 Новини
Злодій з Львівщини виніс з квартири волинянина понад 100 тисяч гривень
Йому загрожує до шести років позбавлення волі.

17 листопада, 11:30 Новини
Які квартири можна купити у новому будинку «Супернови». ПЛАНУВАННЯ*
У всіх квартирах є лоджії, а розмір кухні дозволяє облаштувати не тільки зону приготування їжі, а й місце для відпочинку.

17 листопада, 11:25 Новини
Волинян просять повідомляти в СБУ про підозрілі ситуації на кордоні
На фоні міграційної кризи в Білорусі Служба безпеки України, Національна поліція та Прикордонна служба звертають особливу увагу на захищеність кордону

17 листопада, 11:13 Новини
У Луцьку суттєво підняли вартість вивезення сміття
Плата за вивіз сміття зросте на майже 10 гривень і становитиме 26,33 грн з людини

17 листопада, 10:55 Новини
«Ваш транспорт небезпечний»: у Луцьку з перевізником розірвали договір
Договір розірвали через постійні порушення.

17 листопада, 10:45 Новини
51 тис штрафу та 10 років без посвідчення: у Луцьку п’яний водій в’їхав в припарковане авто
Суд призначив йому покарання у виді трьох тисяч неоподаткованих мінімумів доходів громадян, що становить 51 тисячу гривень.

17 листопада, 10:25 Новини
Свято наближається: де і коли у Луцьку продаватимуть новорічні ялинки
У Луцьку визначили перелік локацій, на яких дозволили розміщувати пункти продажу хвойних дерев до новорічних та різдвяних свят.

17 листопада, 10:03 Новини
Яка ситуація у ковідному шпиталі в Боголюбах станом на 17 листопада
146 людей знаходиться під високими потоками кисню.

17 листопада, 09:58 Новини
Благодійники подарували луцькій лікарні атроскопічне обладнання
Атроскопічне обладнання необхідне для здійснення малоінвазивних, атроскопічних операцій на колінних, плечових та інших суглобах.

17 листопада, 09:40 Новини
Волинянину, який торгував наркотиками, дали 6 років тюрми
Також у нього конфіскують усе майно.
17 листопада, 09:26 Новини
На Волині – рекордна кількість хворих на коронавірус за добу, 17 людей померло
Зареєстровано 731 новий випадок коронавірусної хвороби COVID-19 (з них дітей –82, медпрацівників – 15).

17 листопада, 09:05 Новини
Стартувало будівництво другої черги ЖК «StyleUp»: особливості та ціни*
Забудовник «Континіум Девелопмент» розпочав зведення другої черги свого першого на Волині житлового комплексу – «StyleUp».

17 листопада, 09:02 Новини
Повідомили статистику щодо коронавірусу в Україні за минулу добу
Добові показники захворюваності та смертності тримаються на високому рівні

17 листопада, 08:35 Новини
Волинська лікарка розповіла, чому не можна «вправляти диски»
Завідувачка неврологічним відділенням КНП «Нововлинська центральна міська лікарня», лікар-невропатолог Ольга Доманська розвінчала міфи про «вправляння

17 листопада, 07:33 Новини
В Україні продовжать підвищуватися ціни на хліб
Припинення зростання цін на хліб очікувати не доводиться. Багато факторів свідчать про те, що надалі показник не зможе тішити покупців.

17 листопада, 06:31 Новини
Компанія Pfizer поділиться рецептом таблеток від коронавірусу
Компанія Pfizer підписала угоду з Патентним пулом лікарських засобів, яка дасть змогу іншим виробляти їхні експериментальні ліки від коронавірусу COVI

17 листопада, 05:27 Новини
Дев'ятирічні футболісти «Волині» виграли турнір «UraganCup»
«Волинь» U-9 під керівництвом Романа Іваницького вдало з’їздила на турнір «UraganCup», що відбувався в Івано-Франківську.

17 листопада, 03:48 Новини
Перша українська електровантажівка: що про неї відомо і скільки коштуватиме. ФОТО
Розробки українського комерційного електромобіля CoolOn розпочалися кілька років тому, але інженери постійно модифікували своє авто і вийшли на досить

17 листопада, 02:16 Новини
Волинський тренер потрапив на обкладинку всеукраїнських змагань. ФОТО
Тренер з Володимира-Волинського потрапив на обкладинку всеукраїнських змагань SPARTAN.

17 листопада, 01:13 Новини
Де та скільки у світі платять вакцинованим громадянам
Президент Володимир Зеленський запропонував українцям фінансовий стимул за повну вакцинацію від коронавірусу. Кожен вакцинований зможе отримати по 1 0

17 листопада, 00:00 Новини
17 листопада на Волині: гортаючи календар
День народження 17 листопада святкують луцький бізнесмен Роман Хорзов (на фото) та журналістка Вікторія Семенюк-Денисюк.
Останні новини
У місті на Волині - нові тарифи на воду
Сьогодні, 14:09
Курс валют на 30 травня: скільки коштують долар, євро і злотий
Сьогодні, 11:17

